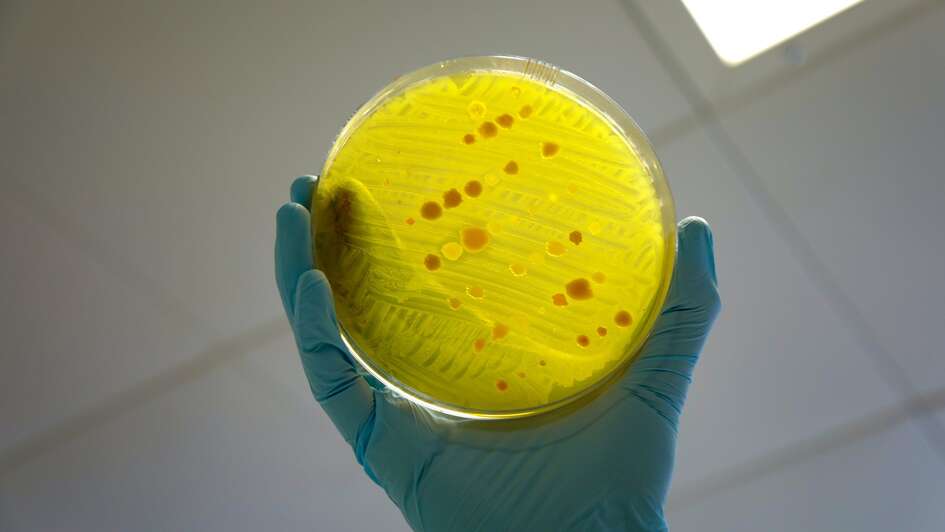

Wie Tierhaltung zunehmend zu Antibiotikaresistenzen in der Welt beiträgt
Bis 2030 werden China, Brasilien, Indien, Indonesien und die USA die meisten antimikrobiell wirksamen Substanzen in der Tierhaltung einsetzen. Nur globale One-Health-Strategien können Resistenzen zurückdrängen.
Der Einsatz von Antibiotika in der Therapie von Infektionskrankheiten (Antibiose) hat in den vergangenen 80 Jahren zu einer enormen Entwicklung der globalen Gesundheit beigetragen. Millionen Menschen überleben Infektionen, die früher lebensbedrohlich waren, Antibiotika ermöglichen lebensrettende medizinische Maßnahmen, wie Organtransplantationen oder schwierige Operationen (Hutchings et al., 2019; Wall, 2019). Jedoch hat die unreflektierte und teils missbräuchliche Anwendung von Antibiotika zu einem raschen und nicht kontrollierbaren Anstieg von antimikrobiellen Resistenzen (AMR) geführt: sowohl bei der Behandlung von viralen Infektionskrankheiten wie auch zur Prophylaxe oder als Leistungsförderer in Tierhaltungen oder durch massenhaften nicht-selektive Einsatz z.B. in Aquakulturen weltweit.
Zugleich ist die Entwicklung neuer antimikrobiell wirksamer Substanzen (AMS) begrenzt, so dass wir immer häufiger mit unbehandelbaren bakteriellen Infektionen konfrontiert werden (Prescott, 2014). Die Weltgesundheitsorganisation (WHO) stuft Antibiotikaresistenz als „globale Sicherheitsbedrohung“ und damit als eine der zehn größten Gesundheitsbedrohungen für die Menschheit ein.
Es steht außer Frage, dass der Einsatz großer Mengen von AMS in der Nutztierhaltung eine entscheidende Rolle bei der Entstehung von AMR spielt, insbesondere durch vorbeugende antimikrobielle Behandlungen in intensiven Tierhaltungen und den Einsatz von AMS in subtherapeutischen Dosen als Masthilfsmittel und Leistungsförderer. Dass dafür in erheblichem Maß Wirkstoffe bzw. Wirkstoffgruppen zum Einsatz kommen, die in der Humanmedizin essenziell für die Behandlung von Infektionen sind, verschärft das Problem (Van Boeckel et al., 2015).
Wie und warum entstehen Resistenzen
Grundsätzlich beinhaltet die AMR-Entstehung zwei Aspekte: einerseits entstehen im Tier durch Selektion resistente Bakterien, wenn AMS regelmäßig, oder unsachgemäß, oder subtherapeutisch eingesetzt werden. Sie werden über die Umwelt und Lebensmittel auf den Menschen, oder durch direkten Kontakt auf Tierhalter und Tierbetreuer übertragen. Andererseits gelangen AMS in die Umwelt und in den Boden in der Umgebung von Tierhaltungen (Emissionen und Ausscheidungen) und von Produktionsstätten (Emissionen und Abwässer). Dadurch entsteht ein Selektionsdruck und es entwickeln sich neue resistente Bakterien, die sich weiter ausbreiten können und über Lebensmittel entweder auf den Menschen oder über Futtermittel in die Tierhaltungen übertragen werden können (Agramont et al., 2020).
Es gibt drei Mechanismen, wie Bakterien sich der Wirkung von AMS entziehen und AMR entwickeln können. (1) Grundlage hierfür können Mutationen im Genom der Bakterien sein (intrinsische Resistenzen). Es können auch Resistenzmechanismen/-eigenschaften über mobile genetische Elemente (Plasmide, Transposons etc.) von einer Bakterienzelle zu einer anderen übertragen werden (horizontaler Gentransfer, erworbene Resistenz, Uluseker et al., 2021). Diese Art der Übertragung von Resistenzgenen ist für die schnelle Ausbreitung und Weiterentwicklung von sog. multiresistenten Bakterien unter dem Selektionsdruck der vorhandenen AMS in Mensch, Tier und Umwelt von herausgehobener Bedeutung.
Globale Trends: Einsatz von AMS in der Tierhaltung

Der Hauptgrund für die Entwicklung und Verbreitung von AMR ist ohne Zweifel mit anthropogenen Tätigkeiten verbunden. Es gibt eindeutige Korrelationen zwischen der Menge der in den Tierhaltungen eingesetzten AMS und der Häufigkeit von AMR in Mensch und Tier (Chantziaras et al., 2014). Insgesamt gesehen, handelt es sich bei den AMR um ein komplexes und grenzüberschreitendes Problem – sowohl im Bereich der Entstehung als auch der Übertragung vom Tier und der Umwelt auf den Menschen, bei dem als Konsequenz dieser Kausalkette schwerwiegende gesundheitlich Folgen für Mensch und Tier in Form von therapieresistenten bakteriellen Erkrankungen entstehen (Marti et al., 2014; Burow and Käsbohrer, 2017; Aslam et al. 2021).
Globale Anstrengungen gegen Resistenzen erforderlich
Eine aktuelle und sehr umfassende Studie für das Jahr 2019 (Antimicrobial Resistance Collaborators, 2022) kommt zu dem Ergebnis, dass weltweit 4,95 Millionen Menschen aufgrund von Krankheiten starben, die mit AMR in Verbindung stehen. Davon waren 1,27 Millionen Todesfälle eine direkte Folge von AMR.
Daher sind, um AMR zu bekämpfen, globale, strategisch-koordinierte, sektorübergreifende und transdisziplinäre Anstrengungen unter Berücksichtigung des Netzwerks zwischen Mensch, Tier und Umwelt notwendig. Sie müssen Regierungen, wissenschaftliche Einrichtungen, Industrie, Landwirtschaft, Gesundheitsdienstleister und die Öffentlichkeit einbeziehen (i.e. Global One Health-Strategie; Ogyu et al., 2020; Aslam et al., 2021; Yin et al., 2021).
Aktuell nimmt weltweit der Einsatz von AMS und somit die AMS-Gesamtbelastung weiter zu. In der Tierhaltung ist dies insbesondere einer enorm gestiegenen Nachfrage nach tierischem Protein geschuldet, wie man am Beispiel Asiens sieht. So stieg die tägliche Aufnahme pro Kopf von tierischem Protein von 7 g im Jahr 1965 auf etwa 25 g im Jahr 2013 (Van Boeckel et al., 2015). Um diesen Bedarf zu decken, werden immer mehr Tiere auf engerem Raum gehalten und v.a. in Ländern wie Brasilien, Russland, Indien, China und Südafrika extensivere Tierhaltung in effizientere Intensivtierhaltungen umgebaut. Diese benötigen große Mengen an Antibiotika, um zu funktionieren. In der Humanmedizin nimmt der Verbrauch aufgrund der gestiegenen Verfügbarkeit in vielen Ländern stark zu.
Insgesamt ist der Verbrauch von Antibiotika weltweit im humanmedizinischen Bereich zwischen 2000 und 2015 um 65 Prozent gestiegen. Für den Einsatz im Tierbereich gibt es wenig verlässliche Zahlen, jedoch gehen Forscher aktuell von einem Anstieg des Verbrauchs um 67 Prozent von 2010 bis 2030 aus, wobei voraussichtlich im Jahr 2030 die meisten AMS in Tierhaltungen in China, Brasilien, Indien, Indonesien und USA eingesetzt werden (Van Boeckel et al., 2015) (Yin et al., 2021; Klein et al., 2018).
Besondere Stellung China und Indien
Eine besondere Stellung im Bereich der AMS nehmen China und Indien ein. Dort werden große Mengen produziert. Etwa 42 Prozent der weltweiten AMS-Exporte stammen aus China, weitere rund 9 Prozent aus Indien, und somit über 50 Prozent aller AMS-Exporte aus diesen beiden Ländern (Yin et al., 2021). Dies bedeutet, dass durch Emissionen und Abwässer der pharmazeutischen Industrie zusätzlich zu den Emissionen aus Tierhaltungen große Mengen von AMS in die Umwelt gelangen, wo sie für die Entstehung und Verbreitung von AMR sorgen (Larsson und Flach, 2022).
In der Europäischen Union ist der Einsatz von AMS als Wachstumsförderer in der Tierhaltung seit Jahren verboten. Weitere Maßnahmen zur Begrenzung der Entstehung und Vermeidung von AMR wurden durch die neue europäische Tierarzneimittel-Gesetzgebung mit Inkrafttreten zum 28. Januar 2022 (EU-Verordnung 2019/6) ergriffen. Dazu gehören strenge Indikationsregeln für den AMS-Einsatz bei Tieren, die Beschränkung auf den Humaneinsatz, oder eine genaue Datenerhebung zum Einsatz von AMS in Tierhaltungen. Dagegen werden in vielen Ländern, darunter wiederum China und Indien, weiterhin in der Tierhaltung in großem Umfang AMS als Wachstumsförderer eingesetzt, die in der EU verboten sind, wie z.B. Chloramphenicol (Reserve-Antibiotika) sowie prophylaktische AMS in sub-therapeutischen Dosen (Hu und Cheng, 2018).

Pläne zur Eindämmung und Problemlösung
Inzwischen ist jedoch das Problembewusstsein für AMR auch in Ländern wie China und Indien gestiegen (Wang et al., 2016, Qu et al., 2019, Taneja und Sharma, 2019, Yin et al., 2021). So hat die chinesische Regierung Maßnahmen ergriffen, um die therapeutisch nicht notwendige Anwendung von mehr als 150 antimikrobiell wirksamen Produkten bei Tieren, die Lebensmittel liefern, zu reduzieren. Auch weltweit wurden und werden große Anstrengungen unternommen, um die allgemeine AMR-Situation zu verbessern, den AMS-Einsatz zu reduzieren, die AMR-Situation weltweit besser zu überwachen und zu beurteilen, und Antibiotika-Kontaminationen in der Umwelt zu verringern:
1. Reduktion des AMS-Einsatzes
Um die Entwicklung von AMR kontrollieren und bekämpfen zu können, ist es notwendig, AMS sowohl in der Humanmedizin als auch in den Tierhaltungen in kleineren Mengen und zielgerichteter zu verabreichen. Dazu wurden Richtlinien für den korrekten Einsatz von AMS in der Human- und Veterinärmedizin implementiert, die kontinuierlich verbessert werden. Auch Aufklärungsprogramme für medizinisches Personal und die Bevölkerung hinsichtlich Hygiene und AMS-Einsatz sowie die Einführung von Verschreibungspflichten für die Human- und Veterinärmedizin, die AMS weniger allgemein verfügbar machen, können zu einem reduzierten Einsatz beitragen (Xiao, 2018). In den Tierhaltungen sind zudem u.a. eine Verbesserung der Haltungsbedingungen und damit der Stressreduktion für Tiere sowie Maßnahmen der Biosicherheit zur Senkung des Infektionsdrucks und die Entwicklung von Impfprogrammen wichtig.
2. Überwachung der AMR-Situation
Zur wichtigen Beurteilung der aktuellen Lage und der Überwachung künftiger Entwicklungen von Resistenzen wurden unterschiedliche nationale und supranationale Surveillance Programme eingeführt. Dabei werden aber meist nur Bakterienisolate aus erkrankten humanen Patienten untersucht. Diese Art des Monitorings zeigt zwar die bedrohliche Situation eines Therapienotstandes. Sie wird aber nicht der Komplexität der gesamten Entstehungs- und Verbreitungsproblematik von AMR gerecht. Denn dafür sind integrative Daten („Big Data“) aus allen beteiligten Systemen – Gesundheitswesen, Umwelt, Landwirtschaft und Tierhaltung – notwendig, um die komplexen Zusammenhänge weiter zu erforschen. In den vergangenen 40 Jahren wurden daher Programme schrittweise weiterentwickelt: von einer Überwachung der klinischen AMR zu gemeinsamen Maßnahmen gegen AMR in mehreren beteiligten Bereichen.
Aktuelle Monitoring-Programme sind immer stärker darauf ausgerichtet, durch eine räumlich und zeitlich gekoppelte Untersuchung von Bakterienisolaten aus Menschen, Tieren und der Umwelt die Frage nach dem Ursprung der Resistenz und einer möglichen Übertragung der Resistenzmechanismen in den medizinischen Bereich zu beantworten. Dadurch sollen die Hotspots der Resistenzentwicklung und -weiterverbreitung identifiziert (Humanmedizin, Tierhaltung, Umwelt) und effiziente Bekämpfungsstrategien erarbeitet bzw. präventive Vorkehrungen integriert werden.
Eine Prävention ist gerade in den einkommensschwachen und den Schwellenländern (LIC, MIC) von besonderer Bedeutung, in denen die Verwendung von AMS durch eine breitere Verfügbarkeit und die Intensivierung der Tierproduktion erst noch ansteigt. Hier können durch eine umsichtige Verwendung (Labordiagnostik, Verschreibung, Therapieprogramme etc.), entsprechende Biosicherheit in den Tierhaltungen, alternative Therapien (z.B. Phagentherapie), aber auch durch die Vermittlung eines Problembewusstseins für AMR noch im Anfangsstadium des breiten AMS-Einsatzes wirksame Beiträge geleistet werden.
3. Vermeidung der Kontamination der Umwelt durch Antibiotika
Daneben gibt es verschiedene Ansatzmöglichkeiten, AMS und AMR in Kläranlagen aus Abwässern durch die Einführung weiterer Reinigungsschritte zu eliminieren. Neben physikalischen Methoden (wie Membrantrennverfahren, UV-Bestrahlung) können biologische (z.B. aerobe und anaerobe Bioreaktoren, Belebtschlammverfahren) und chemische Verfahren (photolytische Oxidation oder Ozonierung) eingesetzt werden (Uluseker et al. 2021). Mehr Beachtung sollten mögliche biotechnologische Verfahren (z.B. Kompostierung oder Biogasfermentation) finden, die den Eintrags von AMS, antibiotikaresistenten Bakterien und AMR über die Gülle in die Umwelt verringern. Hierzu wurden bereits verschiedene Studien unter anderem auch in China durchgeführt (Huang et al, 2019; Keenum et al. 2021).
Grundlage für jegliche AMR-Bekämpfung ist der Aufbau von Laborkapazitäten, die Entwicklung von Standardmethoden für den Nachweis von AMR, sowie der Aufbau von Infrastruktur zur Erfassung der AMR-Prävalenzen und deren geografischen Verbreitung. Nur so lassen sich Vergleiche zwischen Ländern ziehen und ergriffene Maßnahmen beurteilen (Apisarnthanarak et al., 2022). Außerdem sollten strenge Grenzwerte festgelegt werden für die Freisetzung von AMS aus Krankenhäusern, der pharmazeutischen Industrie und großen Tierhaltungen – zusammen mit Grenzwerten für die Freisetzung von Metallrückständen, Bioziden und anderen Arzneimitteln, die die Ko-Selektivität von AMR fördern können.
Zusammenfassend ist festzustellen, dass das Bewusstsein für die Resistenzproblematik als komplexes transdisziplinäres und globales Gesundheitsproblem auf allen Ebenen immer mehr vorhanden ist. Es konnten sowohl nationale wie auch globale Maßnahmen in den beschriebenen Bereichen erfolgreich implementiert werden (z.B. Überwachungsprogamme, Vorgaben zur umsichtigen Anwendung von AMS in der Tierhaltung etc.). Obwohl in der Tierhaltung in einzelnen Ländern der Welt (z.B. in Deutschland und Europa) AMS-Verbrauchsmengen erheblich gesunken sind, sollte nicht vergessen werden, dass weltweit neben der Quantität auch die Qualität des Antibiotikaeinsatzes (Labordiagnostik, richtige Indikation, Dauer der Therapie, Umweltrelevanz der Wirkstoffe etc.) verbessert werden muss. Dies gilt besonders in den Ländern, in denen der Einsatz der AMS in der Humanmedizin und in der Tierhaltung erst noch intensiviert werden wird.


Literatur
- Agramont, J., Gutiérrez-Cortez, S., Joffré, E., Sjöling, Å., & Calderon Toledo, C. (2020). Fecal Pollution Drives Antibiotic Resistance and Class 1 Integron Abundance in Aquatic Environments of the Bolivian Andes Impacted by Mining and Wastewater. Microorganisms, 8(8), 1122. https://doi.org/10.3390/microorganisms8081122.
- Anonymus, 2018: VERORDNUNG (EU) 2019/6 DES EUROPÄISCHEN PARLAMENTS UND DES RATES vom 11. Dezember 2018 über Tierarzneimittel und zur Aufhebung der Richtlinie 2001/82/EG
- Antimicrobial Resistance Collaborators (2022). Global burden of bacterial antimicrobial resistance in 2019: a systematic analysis. Lancet (London, England), 399(10325), 629–655. doi.org/10.1016/S0140-6736(21)02724-0
- Apisarnthanarak, A., Bin Kim, H., Moore, L., Xiao, Y., Singh, S., Doi, Y., Kwa, A. L., Ponnampalavanar, S., Cao, Q., Kim, S. W., Lee, H., & Santanirand, P. (2022). Utility and Applicability of Rapid Diagnostic Testing in Antimicrobial Stewardship in the Asia-Pacific Region: A Delphi Consensus. Clinical infectious diseases : an official publication of the Infectious Diseases Society of America, 74(11), 2067–2076. doi.org/10.1093/cid/ciab910.
- Aslam, B., Khurshid, M., Arshad, M. I., Muzammil, S., Rasool, M., Yasmeen, N., Shah, T., Chaudhry, T. H., Rasool, M. H., Shahid, A., Xueshan, X., & Baloch, Z. (2021). Antibiotic Resistance: One Health One World Outlook. Frontiers in cellular and infection microbiology, 11, 771510. https://doi.org/10.3389/fcimb.2021.771510.
- Burow, E., and Käsbohrer, A. (2017). Risk Factors for Antimicrobial Resistance in Escherichia Coli in Pigs Receiving Oral Antimicrobial Treatment: A Systematic Review. Microb. Drug Resist. (Larchmont N.Y.) 23 (2), 194–205. doi: 10.1089/dr.2015.0318.
- Chantziaras, I., Boyen, F., Callens, B., & Dewulf, J. (2014). Correlation between veterinary antimicrobial use and antimicrobial resistance in food-producing animals: a report on seven countries. The Journal of antimicrobial chemotherapy, 69(3), 827–834. doi.org/10.1093/jac/dkt443
- Hu, Y., & Cheng, H. (2018). Elevated antimicrobial residues in animal food products call for institutional changes on veterinary drug management and animal food product surveillance in China. International journal of antimicrobial agents, 51(1), 165–166. doi.org/10.1016/j.ijantimicag.2017.11.016.
- Huang, X., Zheng, J., Tian, S., Liu, C., Liu, L., Wei, L., Fan, H., Zhang, T., Wang, L., Zhu, G., & Xu, K. (2019). Higher Temperatures Do Not Always Achieve Better Antibiotic Resistance Gene Removal in Anaerobic Digestion of Swine Manure. Applied and environmental microbiology, 85(7), e02878-18. doi.org/10.1128/AEM.02878-18 [Titel anhand dieser DOI in Citavi-Projekt übernehmen]
- Hutchings, M.I., Truman, A.W., Wilkinson, B. (2019). Antibiotics: past, present and future, Current Opinion in Microbiology, Volume 51, 72-80. ISSN 1369-5274, https://doi.org/10.1016/j.mib.2019.10.008.
- Keenum, I., Williams, R. K., Ray, P., Garner, E. D., Knowlton, K. F., & Pruden, A. (2021). Combined effects of composting and antibiotic administration on cattle manure-borne antibiotic resistance genes. Microbiome, 9(1), 81. doi.org/10.1186/s40168-021-01006-z [Titel anhand dieser DOI in Citavi-Projekt übernehmen]
- Klein, E. Y., Van Boeckel, T. P., Martinez, E. M., Pant, S., Gandra, S., Levin, S. A., Goossens, H., & Laxminarayan, R. (2018). Global increase and geographic convergence in antibiotic consumption between 2000 and 2015. Proceedings of the National Academy of Sciences of the United States of America, 115(15), E3463–E3470. doi.org/10.1073/pnas.1717295115.
- Larsson, D.G.J., Flach, C.F. (2022). Antibiotic resistance in the environment. Nat Rev Microbiol. 2022 20(5), 257-269. doi: 10.1038/s41579-021-00649-x.
- Marti, E., Variatza, E., and Balcazar, J. L. (2014). The Role of Aquatic Ecosystems as Reservoirs of Antibiotic Resistance. Trends Microbiol. 22 (1), 36–41. doi: 10.1016/j.tim.2013.11.001
- Ogyu, A., Chan, O., Littmann, J., Pang, H. H., Lining, X., Liu, P., Matsunaga, N., Ohmagari, N., Fukuda, K., & Wernli, D. (2020). National action to combat AMR: a One-Health approach to assess policy priorities in action plans. BMJ global health, 5(7), e002427. https://doi.org/10.1136/bmjgh-2020-002427.
- Prescott J. F. (2014). The resistance tsunami, antimicrobial stewardship, and the golden age of microbiology. Veterinary microbiology, 171(3-4), 273–278. doi.org/10.1016/j.vetmic.2014.02.035
- Qu, J., Huang, Y., & Lv, X. (2019). Crisis of Antimicrobial Resistance in China: Now and the Future. Frontiers in microbiology, 10, 2240. doi.org/10.3389/fmicb.2019.02240.
- Taneja, N., & Sharma, M. (2019). Antimicrobial resistance in the environment: The Indian scenario. The Indian journal of medical research, 149(2), 119–128. doi.org/10.4103/ijmr.IJMR_331_18
- Uluseker, C., Kaster, K. M., Thorsen, K., Basiry, D., Shobana, S., Jain, M., Kumar, G., Kommedal, R., & Pala-Ozkok, I. (2021). A Review on Occurrence and Spread of Antibiotic Resistance in Wastewaters and in Wastewater Treatment Plants: Mechanisms and Perspectives. Frontiers in microbiology, 12, 717809. https://doi.org/10.3389/fmicb.2021.717809
- Van Boeckel, T. P., Brower, C., Gilbert, M., Grenfell, B. T., Levin, S. A., Robinson, T. P., Teillant, A., & Laxminarayan, R. (2015). Global trends in antimicrobial use in food animals. Proceedings of the National Academy of Sciences of the United States of America, 112(18), 5649–5654. doi.org/10.1073/pnas.1503141112
- Wall, S. (2019). Prevention of antibiotic resistance - an epidemiological scoping review to identify research categories and knowledge gaps. Glob Health Action 13;12, 1756191. doi: 10.1080/16549716.2020.1756191. PMID: 32475304; PMCID: PMC7782542.
- Wang, L., Zhang, X., Liang, X., and Bloom, G. (2016). Addressing antimicrobial resistance in China: policy implementation in a complex context. Global. Health 12:30. doi: 10.1186/s12992-016-0167-167
- Xiao, Y. (2018). Antimicrobial Stewardship in China: Systems, Actions and Future Strategies. Clin Infect Dis. 13;67(suppl_2), 135-S141. doi: 10.1093/cid/ciy641.
- Yin. J., Wang, Y., Xu, X., Liu, Y., Yao, L., Sun, Q. (2021). The Progress of Global Antimicrobial Resistance Governance and Its Implication to China: A Review. Antibiotics (Basel). 6;10(11), 1356. doi: 10.3390/antibiotics10111356.
- Zhang, Y. Y., Zhuang, Y., Geng, J. J., Ren, H. Q., Xu, K., and Ding, L. L. (2016). Reduction of antibiotic resistance genes in municipal wastewater effluent by advanced oxidation processes. Sci. Total Environ. 15, 184–191. doi: 10.1016/j.scitotenv.2016.01.078
Fußnoten:
- Der erste Mechanismus führt über eine Produktion von Enzymen zum Abbau von AMS in der bakteriellen Zelle. Der zweite Ansatz der Bakterien liegt in einer Verringerung der intrazellulären Konzentration des AMS entweder durch eine Verhinderung der Aufnahme in die Zelle oder eines aktiven Heraustransportierens aus der Zelle (Efflux-Pumpen). Der dritte Mechanismus beruht darauf, dass Bakterien die Angriffsorte der AMS modifizieren oder sogar alternative Bindeproteine zur Verfügung stellen, so dass die Wirkung der AMS verhindert wird.




